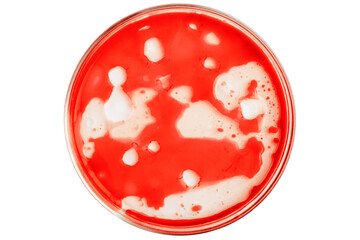
Petri dish with bloody red liquid. On a blank background

Ekologiczny Druk w Technologii HP Latex
Technologia HP Latex to tusze oparte w 100% na ekologicznych składnikach. Jest to jedyny na świecie tusz, który może być stosowany nie tylko na zewnątrz, ale także w pomieszczeniach. Technologia zastosowana do stworzenia tego tuszu daje nie tylko spore możliwości zastosowań, ale także odznacza się trwałością, którą można porównać z trwałością wydruków ekosolwentowych.
Dla wielu użytkowników będzie z pewnością istotny także aspekt ekologiczności. Z uwagi na fakt, że tusze latexowe oparte są na bazie wody nie istnieje niebezpieczeństwo pojawiania się nieprzyjemnych zapachów, które mogą być szkodliwe podczas pracy maszyn. Zamknięty obieg termicznego utrwalania i suszenia sprawia, że wykorzystanie gotowych wydruków może być natychmiastowe.
Druk zgodny z rygorystycznymi europejskimi normami dla reklamy in- i outdoorowej. Ekologiczność tuszy została potwierdzona certyfikatami UL ECOLOGO i UL GREENGUARD GOLD, a wydruki spełniają normy AgBB.
Dzięki technologii druku HP Latex możliwe stało się stworzenie proekologicznych produktów końcowych coraz częściej wymaganych przez klientów. Technologia gwarantuje wydruki najwyższej jakości, które bez względu na czas są bezwonne i nietoksyczne.
Druk HP Latex jest bezpieczny dla użytkowników aplikacji oraz operatorów urządzeń. Nie ma negatywnego wpływu na środowisko. Podczas drukowania nie uwalniają się żadne toksyczne substancje, które mogłyby stanowić zagrożenie dla życia lub zdrowia.
Urządzenia HP Latex posiadają certyfikat ENERGY STAR, co oznacza, że spełniają surowe wytyczne w zakresie energooszczędności
Dla wielu użytkowników będzie z pewnością istotny także aspekt ekologiczności. Z uwagi na fakt, że tusze latexowe oparte są na bazie wody nie istnieje niebezpieczeństwo pojawiania się nieprzyjemnych zapachów, które mogą być szkodliwe podczas pracy maszyn. Zamknięty obieg termicznego utrwalania i suszenia sprawia, że wykorzystanie gotowych wydruków może być natychmiastowe.
Druk zgodny z rygorystycznymi europejskimi normami dla reklamy in- i outdoorowej. Ekologiczność tuszy została potwierdzona certyfikatami UL ECOLOGO i UL GREENGUARD GOLD, a wydruki spełniają normy AgBB.
Dzięki technologii druku HP Latex możliwe stało się stworzenie proekologicznych produktów końcowych coraz częściej wymaganych przez klientów. Technologia gwarantuje wydruki najwyższej jakości, które bez względu na czas są bezwonne i nietoksyczne.
Druk HP Latex jest bezpieczny dla użytkowników aplikacji oraz operatorów urządzeń. Nie ma negatywnego wpływu na środowisko. Podczas drukowania nie uwalniają się żadne toksyczne substancje, które mogłyby stanowić zagrożenie dla życia lub zdrowia.
Urządzenia HP Latex posiadają certyfikat ENERGY STAR, co oznacza, że spełniają surowe wytyczne w zakresie energooszczędności